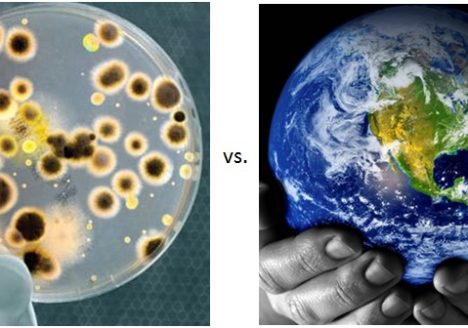

Author / liedloff
-
2021. évi adójóváírás 2.0 verzió
A politikai boszorkánykonyhákból terjengő illatok arra engednek következtetni, hogy választási év közeledik. Az igéret dömping egyik elemeként immár kőbe van vésve – ha nem is gránitszilárdsággal, hiszen a vészhelyzetre való tekintettel most…
2021.10.13. -
Shakespeare-i idők, avagy Hamlet dilemmája – Pénzpiaci összefoglaló 2021. III. negyedév
Nagy tétben mernénk arra fogadni, hogy a mostani időszak nemcsak a járványkezelés nagy könyvébe fog bekerülni, de komoly fejezetet fognak neki szentelni a tőkepiacok enciklopédiájában is. Shakespeare óta tudjuk, hogy az ember…
2021.09.24. -
Csecsemőgondozási díj változás 2021 júliusától
2021. július 1-től változik a gyermekek utáni ellátások közül a csecsemőgondozási díj (CSED) mértéke. Erről még 2020-ban döntött az Országgyűlés, azonban most lépett hatályba (2020. évi CXXXIV. törvény) A gyermek születésétől (illetve…
2021.07.01. -
Az infláció, mint új mumus – Pénzpiaci összefoglaló 2021.II. negyedév (2021.06.25)
Az átoltottság folyamatos emelkedésének, a már megfertőződtek immunitásának, a 3. hullám lecsengésének és valamelyest a nyári időszak beköszöntének is köszönhetően a világ – legalábbis annak járványmegelőzésben előrébb tartó része – kezd kikecmeregni…
2021.06.25. -
Nyuszi, talán beteg vagy? – Pénzpiaci összefoglaló 2021.I. negyedév
A tavalyi húsvétra megvett csokinyuszik szavatossága már rég lejárt, de úgy fest, idén megspórolhatjuk a húsvéti ezirányú kiadásainkat. Se locsolóvers, se hímestojás. Lesz mit visszahozni a hagyományőrzőknek. Mindent a COVID-helyzet határoz meg,…
2021.03.29. -
Vakcinára hangolva – Pénzpiaci összefoglaló 2020.IV. negyedév
2020. kétséget kizáróan a koronavírus éveként fog bevonulni a történelembe, reméljük nem úgy, mint a 30 éves háború. Bár egy nehéz évet tudhatunk lassanként magunk mögött, egészségügyi szakemberek szerint összetehetjük a kezünket,…
2020.12.28. -
Vajon nehéz őszünk lesz? – Pénzpiaci összefoglaló 2020.III. negyedév
Nem úgy tűnik, hogy maholnap lecsengene a korona vírus járvány, sőt. Immár masszívan 300 ezer körüli szinten van a napi fertőzésszám a világban, s mára már 31 millióan fertőződtek meg. Az elhunytak…
2020.09.21. -
Újraindítás vagy újratervezés? – Pénzpiaci összefoglaló 2020.II. negyedév
A koronavírus járvány idehaza, sőt Európában is lecsengőben van – legalábbis a számok erre engednek következtetni -, miközben a világ egyes részein még javában emelkedik a fertőzéses esetek száma. Világviszonylatban a megbetegedettek…
2020.03.26. -
Csapataink harcban állnak – Pénzpiaci összefoglaló 2020. I. negyedév
Csapataink harcban állnak és egyelőre nem állunk jól. Egy negyedéve a tőzsdei árfolyamokat illetően arról írtunk, hogy „a fák nem nőnek az égig”, de hogy olyan tarvágás fog bekövetkezni hamarosan, mint amit…
2020.03.26. -
Az égig érő fa története – Pénzpiaci összefoglaló 2019. IV. negyedév
Ki ne ismerné a brókerkörökben gyakran elsütött mondást, hogy a fák nem nőnek az égig. Több éve halljuk – s mi tagadás, valljuk magunk is – ezt arra való figyelmeztetésként, hogy akkora…
2019.12.30.
Legutóbbi bejegyzések
- Megáradt, nem kicsit! – pénzpiaci összefoglaló 2026. II. negyedév
- A nemzetközi helyzet? Fokozódik. – pénzpiaci összefoglaló 2026. I. negyedév
- Bővülő paletta áprilistól! – Új impulzus a portfólióknál
- A fehér karácsony ígérete – pénzpiaci összefoglaló 2025. IV. negyedév
- Természetes vs. mesterséges intelligencia – pénzpiaci összefoglaló 2025. III. negyedév